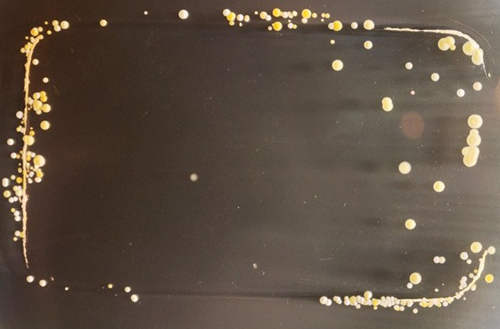
5.jpg

>> Điện thoại di động bẩn gấp 10 lần nắp toilet / Thói quen nên từ bỏ khi dùng đồ công nghệ
Giáo sư Simon Park của Đại học Surrey (Anh) đã yêu cầu các sinh viên trong lớp vi trùng học và y sinh của ông in dấu điện thoại của họ lên một chiếc đĩa có đựng lớp chất kích thích tăng trưởng vi khuẩn. Sau 3 ngày, trên những vết in này đã “nở” ra rất nhiều loại vi khuẩn.
Theo ông Park, hầu hết chúng là những loại vi khuẩn vô hại vẫn thường được tìm thấy trên da người. Tuy nhiên, trong đó cũng có những loại vi khuẩn gây bệnh như staphylococcus aureus. Ông Park không ngạc nhiên trước điều này vì cứ 100 người thì có khoảng 20 người liên tục nhiễm staphylococcus aureus và 60 người cũng bị nhiễm loại vi khuẩn này nhưng không thường xuyên.
Một phát hiện thú vị là trên những chiếc điện thoại không cảm ứng, hầu hết vi khuẩn phát triển ở khu vực bàn phím, trong khi trên điện thoại màn hình cảm ứng, vi khuẩn có ở khắp mọi nơi trên thiết bị
Dưới đây là hình ảnh soi dưới kính hiển vi của các loại vi khuẩn bám trên điện thoại di động:

Theo Wired